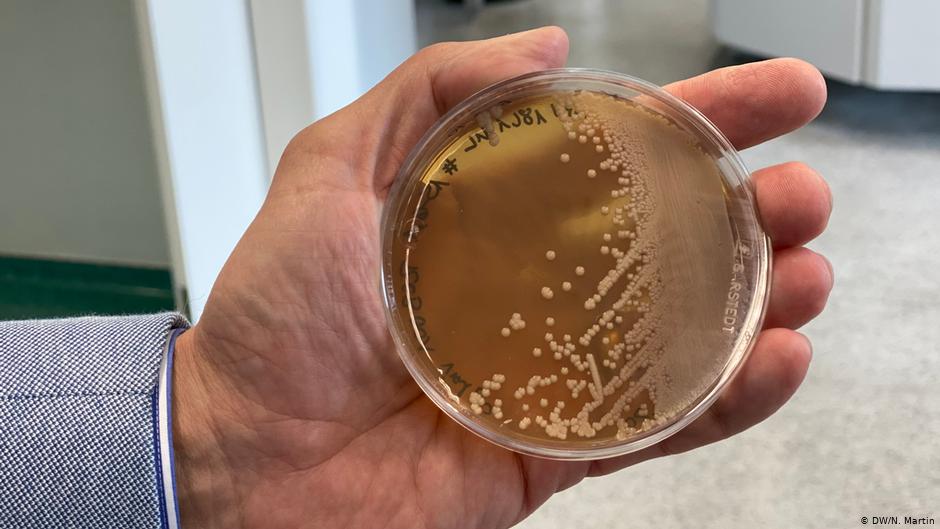

κτός από τις μεγάλες φαρμακευτικές εταιρείες βιοτεχνολογίας που κάνουν αγώνα δρόμου για την παρασκευή και διάθεση του εμβολίου κατά του κορωνοϊού, υπάρχουν κι άλλοι ερευνητές που εργάζονται στο ίδιο αντικείμενο. Ο Μίχαελ Πίοντεκ είναι ανάμεσα σε αυτούς. Από τα φοιτητικά του χρόνια ασχολείται με κύτταρα από μαγιά. Η εταιρεία του Artes Biotechnology έχει ήδη κυκλοφορήσει στο εμπόριο ένα εμβόλιο κατά της ηπατίτιδας Β με βάση τον σακχαρομύκητα, που θεωρείται ο καλύτερα γενετικά μελετημένος οργανισμός με κυτταρικό πυρήνα στον κόσμο.
![]()
«Ασφάλεια, χαμηλή τιμή»

Ο Μίχαελ Πίονκτεκ είναι πολύ αισιόδοξος για το εμβόλιό του
Εδώ και μερικούς μήνες κάνει έρευνες και για το εμβόλιο κατά του κορωνοϊού. Οι καλές ειδήσεις από άλλες φαρμακευτικές εταιρείες του έδωσαν μεγάλη χαρά, αλλά θεωρεί ότι και το δικό του εμβόλιο θα έχει σημαντικές ευκαιρίες στην αγορά λόγω πλεονεκτημάτων σε σχέση με τους ανταγωνιστές του. «Το πρώτο είναι η αποδεδειγμένη ασφάλεια, διότι κυκλοφορούν κι άλλα εμβόλια με βάση τη μαγιά», λέει ο Πίοντεκ. «Διαθέτουμε μια πολύ μεγάλη βάση δεδομένων και γνωρίζουμε πώς επιδρά και ότι δεν βλάπτει κανένα. Το δεύτερο θετικό είναι η τιμή. Με τη μαγιά μπορούμε να παρασκευάσουμε ένα πολύ φτηνό εμβόλιο».
Ο Πίοντεκ έχει άλλη φιλοσοφία από ότι οι μεγάλες φαρμακευτικές εταιρείες. Πουλά την άδεια γύρω από το τεχνολογικό συστατικό του εμβολίου σε εταίρους στην Ασία, οι οποίοι ήδη παράγουν εμβόλιο για την ηπατίτιδα Β σε μεγάλες εγκαταστάσεις. Αυτές οι εταιρείες έχουν την ευλυγισία να αλλάξουν αντικείμενο και να παρασκευάσουν εμβόλιο κατά του Covid-19 για τις μεγάλες αγορές και σε πολύ χαμηλή τιμή. Η μία δόση θα είναι σημαντικά φθηνότερη από αυτή της Moderna και της Biontech, όπως υποστηρίζει ο Πίοντεκ.
Φυλάσσεται σε κανονικό ψυγείο
Η εταιρεία Artes Biotechnology έχει ήδη κυκλοφορήσει στον εμπόριο εμβόλιο κατά της ηπατίτιδας Β με βάση τον σακχαρομύκητα
«Μπορούμε να το διαθέσουμε πολύ πιο φθηνά, γιατί γνωρίζουμε από τα προηγούμενα εμβόλιά μας ότι είμαστε σε θέση να τα παρασκευάσουμε με κόστος κάτω του ενός ευρώ και παρόλα αυτά να επιτύχουμε σχετικά μεγάλα περιθώρια κέρδους» λέει. «Δεν θα πρέπει να περιμένουμε δέκα ή είκοσι χρόνια. Επιπλέον οι εταιρείες, στις οποίες οι μέτοχοι έχουν επενδύσει πολλά χρήματα, θέλουν να πάρουν πίσω κεφάλαιο και κέρδος. Αυτό δεν ισχύει με ‘μας, γιατί εμείς ήδη καταγράφουμε κέρδη και μπορούμε να μεταφέρουμε το μηδαμινό κόστος παραγωγής στους πελάτες, τους αγοραστές και τους ασθενείς».
Ο Μίχαελ Πίοντεκ είναι αισιόδοξος ότι το εμβόλιο που παρασκευάζει στην πόλη Λάνγκενφελντ της Ρηνανίας-Βεστφαλίας θα είναι έτοιμο να κυκλοφορήσει του χρόνου το δεύτερο εξάμηνο.
Σε αντίθεση με τα εμβόλια που βασίζονται στη χρήση του “αγγελιοφόρου” RNA, δεν χρειάζεται να αποθηκευτεί και να μεταφερθεί σε συνθήκες -70 βαθμών. «Είναι αδύνατον να επιτύχετε συνθήκες 70 βαθμών υπό του μηδενός στην Ασία και στην Αφρική» λέει. «Το δικό μας εμβόλιο φυλάσσεται σε κοινά ψυγεία, σε σταθερές συνθήκες. Δεν χρειάζεται ιδιαίτερη υποδομή, ενώ μπορούμε να το μεταφέρουμε πολύ εύκολα».
Νίκολας Μάρτιν
Επιμέλεια: Ειρήνη Αναστασοπούλου



